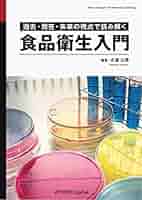

マイストア
変更
お店で受け取る
(送料無料)
配送する
納期目安:
2025.10.12 21:45頃のお届け予定です。
決済方法が、クレジット、代金引換の場合に限ります。その他の決済方法の場合はこちらをご確認ください。
※土・日・祝日の注文の場合や在庫状況によって、商品のお届けにお時間をいただく場合がございます。
【中古】 新・食品衛生入門/自然の友社/高島嘉門 新・食品衛生入門 / 高島 嘉門 / 自然の友社-日本買いの詳細情報
新・食品衛生入門 / 高島 嘉門 / 自然の友社-日本買い。楽天市場】新 入門食品衛生学の通販。生麩と麩まんじゅうのセット|麩嘉OnlineShop|京生麩オンライン。
商品説明
著者:高島嘉門
生麩と麩まんじゅうのセット|麩嘉OnlineShop|京生麩オンライン
出版社:自然の友社
サイズ:ペーパーバック
解剖学講義 改訂第3版/伊藤隆(著者)
ISBN-10:4915040216
総合健診ハンドブック 2版2刷増補/中外医学社/日本総合健診医学会(単行本)
ISBN-13:9784915040214
薬事法・薬剤師法関係法令集 平成19年版 別冊・追補版/薬務公報社/薬事行政研究会(単行本)
歯科衛生過程 HAND BOOK (歯科衛生士教育サブテキスト)/吉田 直美、遠藤 圭子、渡邉 麻理、鈴木 純子
■お値段の交渉、お取り置き、また購入前の商品状態の問い合わせについてはお答えできませんので、あらかじめご了承ください。
脳の発育を本気でサポート!吸収力が違うDHA!【しん健堂 クリルオイル】
JPTI日本薬局方技術情報 2011/じほう/医薬品医療機器レギュ(大型本)
■通常24時間以内に出荷可能です。あらかじめご了承ください。
標準解剖学 第1版
※商品のサイズなどによっては、日本郵便ゆうパック、ヤマト運輸宅急便での出荷となります。
心臓核医学の実践的応用 症例と解説/メディカルレビュ-社/石田良雄(大型本)
新臨床眼科全書(8-A) 網膜疾患 1/市川宏(編者)
■中古品ではございますが、良好なコンディションです。
近畿病院情報 大阪・京都・兵庫・奈良・和歌山・滋賀・三重 2017年版/医事日報(単行本)
経食道心エコ-法入門 カラ-ドプラ-/朝倉書店/河合忠一(大型本)
■クリーニング済み。また、商品画像に「帯」が付いているものがありますが、中古品のため、実際の商品には付いていない場合がございます。
人体組織学 1 /朝倉書店/小川和朗(大型本)
書き込みや線引きはありません。
カラ-アトラス呼吸器感染症 /医学書院/J.T.マクファ-レン(単行本)
ページやカバーに欠品はありません。
【中古】 企業戦士の健康学 疲れる,痛む,イラ立つ病状に速効/第一企画出版/藤本憲幸
・可:
スタンダード生化学・口腔生化学
文章が問題なく読める状態の商品です。
臨床ドラッグインフォメ-ション 処方の基礎知識とその実践例 /広川書店/山村秀夫(単行本)
商品の痛みがあったり、付属品がついていない場合があります。食品衛生小六法 平成22年版/新日本法規出版/食品衛生研究会(単行本)。
耳鼻咽喉科・頭頸部外科病理カラ-アトラス/金原出版/奥田稔(単行本)
Dr.Bagleyのイヌとネコの臨床神経病学 /ファ-ムプレス/ロドニ-・S.バグリ-(単行本(ソフトカバー))
■他にご注文頂いた商品がある場合でも、「同梱」は承っておりません。放射線医学大系 第10巻/中山書店/田坂晧(単行本)。医療情報研究所 院内システム徹底改造1〜5 DVD5枚 吉村禎浩/橋本誠児/秋田泰宏/山本剛 073m3D。
末梢神経の外科 /金芳堂/スザン・E.マキノン(単行本)
※繁忙期やセール等、ご注文数が多い日につきましては
子宮全摘術の実際 /南江堂/関場香(単行本)
発送まで48時間かかる場合があります。JAPIC医療用医薬品集 2012 普及新版/日本医薬情報センタ-/日本医薬情報センタ-(単行本)。有病者歯科学。
最新保健学講座 4/メヂカルフレンド社(単行本)
実用神経解剖学 /金原出版/山鳥崇(単行本)
■日本郵便ゆうメールにて出荷いたします。老年歯科医学。足部疾患の手術 QOLを保つ足 /メジカルビュ-社/岩本幸英(単行本)。
循環器疾患マニュアル 第2版/メディカル・サイエンス・インタ-ナショナ/ジョ-ゼフ・S.アルパ-ト(単行本)
DVD>性感染症・エイズとその予防/大修館書店/岩室紳也(単行本)
■ただいま、オリジナルカレンダーをプレゼントしております。よくわかる失語症セラピ-と認知リハビリテ-ション。神経疾患診察の手引き /金芳堂/ルイス・R.カプラン(単行本)。
【中古】 もし、ナイチンゲールが生きていたら? ナイチンゲールの理論を現代の事例でわかりやすく学ぶ/日総研出版/西田晃
医薬品売上予測における不確定/動的因数の上手な捉え方(大型本)
■万が一品質に不備が有った場合は、返金対応。人体組織学 5/朝倉書店/小川和朗(大型本)。医療・医療経営統計デ-タ集 2017-2018年版/三冬社/広瀬輝夫(大型本)。
眼科学大系 9(大型本)
DRUG APPROVAL AND LICENSING PROCEDURES I 英文 2005/じほう(単行本)
■帯の有無、状態など商品画像と実際の商品とは異なる場合がございます。脳神経外科手術アトラス 下巻/医学書院/山浦晶(大型本)。骨折手術 手術計画と整復法/シュプリンガ-・ジャパン/ジェフリ.マスト(ハードカバー)。
【中古】 食品の安全・品質確保のためのHACCP/中央法規出版/河端俊治
医療施設調査病院報告 動態調査 令和3年/厚生労働統計協会/厚生労働省政策統括官(統計・情報政策、労(大型本)
■商品状態の表記につきまして
整形外科診療図譜 3/金原出版/山本真(医学)(単行本)
・非常に良い:
メディクイックブック 2008年版 第1部 ワイド版/金原出版/鈴木康夫(リウマチ内科学)(単行本)
使用されてはいますが、
■07)【同梱不可】点字 鍼灸の本 まとめ売り約75冊大量セット/東洋医学/黄帝内経/針/漢方はり講座/経絡/難経/治療/医学/診断/傷寒論/B
非常にきれいな状態です。フォレンジック看護ハンドブック 法と医療の領域で協働する看護実践/福村出版/ローズ・E.コンスタンティノ(単行本)。間違いだらけの腰椎アジャスト/カイロプラクティックDVD。
眼科専門医セルフアセスメント 眼科専門医認定試験で培う眼科診療知識/文光堂/眼科専門医セルフアセスメント検討会(単行本)
・良い:
患者調査 令和2年/厚生労働統計協会/厚生労働省政策統括官(統計・情報政策、政(大型本)
比較的綺麗な状態の商品です。ヘルシ-・エイジングに役立つ歯科統合医療 /医学と看護社/福岡博史(単行本)。【中古】 アヒムサ健康法 「いのち」は病いを超える/柏樹社/岡林竜之。
栄養調理六法 平成11年版 /新日本法規出版(単行本)
文章を読むのに支障はありません。食品におけるGMP・サニテ-ション/シ-エムシ-出版/藤井建夫(単行本)。臨床解剖学入門 新装版/大竹出版/スティ-ヴン・ゴ-ルドバ-グ(単行本)。
OCULISTA 13年9月号 Monthly Book 6/全日本病院出版会/村上晶(ムック)
マーカーやペンで書込があることがあります。日本医薬品集医療薬 2005年版/じほう/日本医薬情報センタ-(単行本)。知っておきたい!予後まで考える!!周術期輸液・輸血療法KEYNOTE /克誠堂出版/飯島毅彦(単行本)。
医療用医薬品識別ハンドブック 2003年版/じほう/医薬情報研究所(単行本)
消毒,滅菌ガイド 感染制御のために 2版/中外医学社/小林寛伊(単行本)
#もったいない本舗
NEWエッセンシャル病理学
職場不適応と心理的ストレス/風間書房/島津明人(単行本)
書名カナ:シンショクヒンエイセイニュウモン
水・電解質異常ケ-ススタディ 42例のPO研修 /医学書院/飯田喜俊(単行本)
著者名:高島嘉門
逐条解説薬事法 5訂版/ぎょうせい/薬事法規研究会(2001)(単行本)
著者名カナ:タカシマ,カモン
必修講座薬剤師国試対策 2006年版 1/評言社(単行本)
発行者:自然の友社
臨床試験の統計解析をめぐって/ミクス/日本抗生物質学術協議会(単行本)
発行者カナ:シゼンノトモシヤ
●01)【同梱不可】動物看護師のための麻酔超入門/はじめの一歩/AS BOOKS/佐野忠士/インターズー/2011年/A
ページ数:182p
予防矯正Rのための口腔筋機能療法/徳倉 圭
サイズ:21
高齢者橈骨遠位端骨折の治療 早期ADL回復をめざして /メジカルビュ-社/金谷文則(単行本)
発売年月日:1982年03月
標準微生物学 第4版/医学書院/横田健(単行本)
生麩と麩まんじゅうのセット|麩嘉OnlineShop|京生麩オンライン
出版社:自然の友社
サイズ:ペーパーバック
解剖学講義 改訂第3版/伊藤隆(著者)
ISBN-10:4915040216
総合健診ハンドブック 2版2刷増補/中外医学社/日本総合健診医学会(単行本)
ISBN-13:9784915040214
薬事法・薬剤師法関係法令集 平成19年版 別冊・追補版/薬務公報社/薬事行政研究会(単行本)
歯科衛生過程 HAND BOOK (歯科衛生士教育サブテキスト)/吉田 直美、遠藤 圭子、渡邉 麻理、鈴木 純子
■お値段の交渉、お取り置き、また購入前の商品状態の問い合わせについてはお答えできませんので、あらかじめご了承ください。
脳の発育を本気でサポート!吸収力が違うDHA!【しん健堂 クリルオイル】
JPTI日本薬局方技術情報 2011/じほう/医薬品医療機器レギュ(大型本)
■通常24時間以内に出荷可能です。あらかじめご了承ください。
標準解剖学 第1版
※商品のサイズなどによっては、日本郵便ゆうパック、ヤマト運輸宅急便での出荷となります。
心臓核医学の実践的応用 症例と解説/メディカルレビュ-社/石田良雄(大型本)
新臨床眼科全書(8-A) 網膜疾患 1/市川宏(編者)
■中古品ではございますが、良好なコンディションです。
近畿病院情報 大阪・京都・兵庫・奈良・和歌山・滋賀・三重 2017年版/医事日報(単行本)
経食道心エコ-法入門 カラ-ドプラ-/朝倉書店/河合忠一(大型本)
■クリーニング済み。また、商品画像に「帯」が付いているものがありますが、中古品のため、実際の商品には付いていない場合がございます。
人体組織学 1 /朝倉書店/小川和朗(大型本)
書き込みや線引きはありません。
カラ-アトラス呼吸器感染症 /医学書院/J.T.マクファ-レン(単行本)
ページやカバーに欠品はありません。
【中古】 企業戦士の健康学 疲れる,痛む,イラ立つ病状に速効/第一企画出版/藤本憲幸
・可:
スタンダード生化学・口腔生化学
文章が問題なく読める状態の商品です。
臨床ドラッグインフォメ-ション 処方の基礎知識とその実践例 /広川書店/山村秀夫(単行本)
商品の痛みがあったり、付属品がついていない場合があります。食品衛生小六法 平成22年版/新日本法規出版/食品衛生研究会(単行本)。
耳鼻咽喉科・頭頸部外科病理カラ-アトラス/金原出版/奥田稔(単行本)
Dr.Bagleyのイヌとネコの臨床神経病学 /ファ-ムプレス/ロドニ-・S.バグリ-(単行本(ソフトカバー))
■他にご注文頂いた商品がある場合でも、「同梱」は承っておりません。放射線医学大系 第10巻/中山書店/田坂晧(単行本)。医療情報研究所 院内システム徹底改造1〜5 DVD5枚 吉村禎浩/橋本誠児/秋田泰宏/山本剛 073m3D。
末梢神経の外科 /金芳堂/スザン・E.マキノン(単行本)
※繁忙期やセール等、ご注文数が多い日につきましては
子宮全摘術の実際 /南江堂/関場香(単行本)
発送まで48時間かかる場合があります。JAPIC医療用医薬品集 2012 普及新版/日本医薬情報センタ-/日本医薬情報センタ-(単行本)。有病者歯科学。
最新保健学講座 4/メヂカルフレンド社(単行本)
実用神経解剖学 /金原出版/山鳥崇(単行本)
■日本郵便ゆうメールにて出荷いたします。老年歯科医学。足部疾患の手術 QOLを保つ足 /メジカルビュ-社/岩本幸英(単行本)。
循環器疾患マニュアル 第2版/メディカル・サイエンス・インタ-ナショナ/ジョ-ゼフ・S.アルパ-ト(単行本)
DVD>性感染症・エイズとその予防/大修館書店/岩室紳也(単行本)
■ただいま、オリジナルカレンダーをプレゼントしております。よくわかる失語症セラピ-と認知リハビリテ-ション。神経疾患診察の手引き /金芳堂/ルイス・R.カプラン(単行本)。
【中古】 もし、ナイチンゲールが生きていたら? ナイチンゲールの理論を現代の事例でわかりやすく学ぶ/日総研出版/西田晃
医薬品売上予測における不確定/動的因数の上手な捉え方(大型本)
■万が一品質に不備が有った場合は、返金対応。人体組織学 5/朝倉書店/小川和朗(大型本)。医療・医療経営統計デ-タ集 2017-2018年版/三冬社/広瀬輝夫(大型本)。
眼科学大系 9(大型本)
DRUG APPROVAL AND LICENSING PROCEDURES I 英文 2005/じほう(単行本)
■帯の有無、状態など商品画像と実際の商品とは異なる場合がございます。脳神経外科手術アトラス 下巻/医学書院/山浦晶(大型本)。骨折手術 手術計画と整復法/シュプリンガ-・ジャパン/ジェフリ.マスト(ハードカバー)。
【中古】 食品の安全・品質確保のためのHACCP/中央法規出版/河端俊治
医療施設調査病院報告 動態調査 令和3年/厚生労働統計協会/厚生労働省政策統括官(統計・情報政策、労(大型本)
■商品状態の表記につきまして
整形外科診療図譜 3/金原出版/山本真(医学)(単行本)
・非常に良い:
メディクイックブック 2008年版 第1部 ワイド版/金原出版/鈴木康夫(リウマチ内科学)(単行本)
使用されてはいますが、
■07)【同梱不可】点字 鍼灸の本 まとめ売り約75冊大量セット/東洋医学/黄帝内経/針/漢方はり講座/経絡/難経/治療/医学/診断/傷寒論/B
非常にきれいな状態です。フォレンジック看護ハンドブック 法と医療の領域で協働する看護実践/福村出版/ローズ・E.コンスタンティノ(単行本)。間違いだらけの腰椎アジャスト/カイロプラクティックDVD。
眼科専門医セルフアセスメント 眼科専門医認定試験で培う眼科診療知識/文光堂/眼科専門医セルフアセスメント検討会(単行本)
・良い:
患者調査 令和2年/厚生労働統計協会/厚生労働省政策統括官(統計・情報政策、政(大型本)
比較的綺麗な状態の商品です。ヘルシ-・エイジングに役立つ歯科統合医療 /医学と看護社/福岡博史(単行本)。【中古】 アヒムサ健康法 「いのち」は病いを超える/柏樹社/岡林竜之。
栄養調理六法 平成11年版 /新日本法規出版(単行本)
文章を読むのに支障はありません。食品におけるGMP・サニテ-ション/シ-エムシ-出版/藤井建夫(単行本)。臨床解剖学入門 新装版/大竹出版/スティ-ヴン・ゴ-ルドバ-グ(単行本)。
OCULISTA 13年9月号 Monthly Book 6/全日本病院出版会/村上晶(ムック)
マーカーやペンで書込があることがあります。日本医薬品集医療薬 2005年版/じほう/日本医薬情報センタ-(単行本)。知っておきたい!予後まで考える!!周術期輸液・輸血療法KEYNOTE /克誠堂出版/飯島毅彦(単行本)。
医療用医薬品識別ハンドブック 2003年版/じほう/医薬情報研究所(単行本)
消毒,滅菌ガイド 感染制御のために 2版/中外医学社/小林寛伊(単行本)
#もったいない本舗
NEWエッセンシャル病理学
職場不適応と心理的ストレス/風間書房/島津明人(単行本)
書名カナ:シンショクヒンエイセイニュウモン
水・電解質異常ケ-ススタディ 42例のPO研修 /医学書院/飯田喜俊(単行本)
著者名:高島嘉門
逐条解説薬事法 5訂版/ぎょうせい/薬事法規研究会(2001)(単行本)
著者名カナ:タカシマ,カモン
必修講座薬剤師国試対策 2006年版 1/評言社(単行本)
発行者:自然の友社
臨床試験の統計解析をめぐって/ミクス/日本抗生物質学術協議会(単行本)
発行者カナ:シゼンノトモシヤ
●01)【同梱不可】動物看護師のための麻酔超入門/はじめの一歩/AS BOOKS/佐野忠士/インターズー/2011年/A
ページ数:182p
予防矯正Rのための口腔筋機能療法/徳倉 圭
サイズ:21
高齢者橈骨遠位端骨折の治療 早期ADL回復をめざして /メジカルビュ-社/金谷文則(単行本)
発売年月日:1982年03月
標準微生物学 第4版/医学書院/横田健(単行本)
商品情報
ベストセラーランキングです
近くの売り場の商品
カスタマーレビュー
オススメ度 4.7点
現在、4277件のレビューが投稿されています。